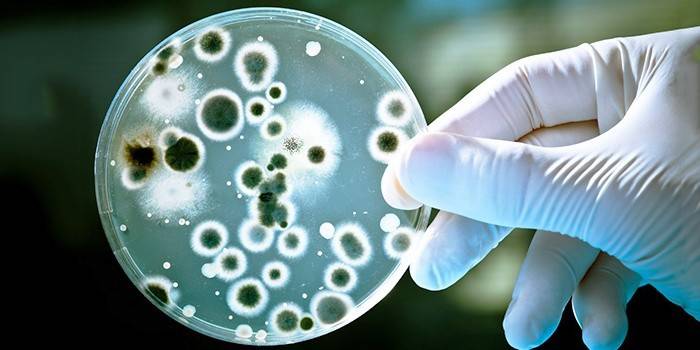

O uso do antibiótico ciprofloxacina
A atitude das pessoas em relação aos antibióticos é muito diferente devido à especificidade de sua ação, mas ninguém nega que a descoberta da droga tenha sido um verdadeiro avanço na medicina. As preparações deste tipo efetivamente lutam a maioria das doenças contagiosas e complicações purulentas. O antibiótico Ciprofloxacina tornou-se um dos medicamentos anti-inflamatórios mais populares deste tipo. É amplamente utilizado por dentistas para tratar doenças otorrinolaringológicas, inflamações infecciosas dos órgãos internos humanos.
O que é ciprofloxacina?
A ação do antibiótico ciprofloxacina baseia-se na sua capacidade de inibir as células bacterianas enzimáticas (DNA girase) com divisão prejudicada, síntese de DNA e crescimento de microorganismos. Segundo o fabricante, ao tomar o medicamento, a resistência a outros antibióticos que não pertencem ao grupo dos inibidores da girase não está desenvolvida. Uma droga eficaz contra infecções que causaram as seguintes cepas:
- estafilococos;
- clamídia;
- legionella;
- micoplasmas;
- enterococos;
- micobactérias.
Se o paciente tiver uma infecção mista (aeróbica e anaeróbica), além do antibiótico ciprofloxacino, o metronidazol ou a lincosamida são prescritos. Isto é devido à sensibilidade moderada de tais patógenos e alguma resistência à droga. A resistência à droga, que é formada gradualmente, tem as seguintes cepas:
- nocardia asteroides;
- ureaplasma urealyticum;
- treponema pallidum;
- estreptococo faecium.
Ao usar a medicação, de 20 a 40% da substância se liga às proteínas plasmáticas. O produto é bem distribuído nos tecidos do corpo através de fluidos biológicos. Às vezes a concentração da droga excede o plasma.A droga é capaz de penetrar no líquido cefalorraquidiano através da placenta, no leite materno, muita substância se acumula na bile. Naturalmente, até 40% da droga é excretada do corpo nas primeiras 24 horas pelos rins, outra parte junto com a bile.
Liberar Formulários
O antibiótico ciprofloxacina tem uma ampla gama de usos, portanto, está disponível em várias formas. Com base na substância activa (fluoroquinolona), existe uma lista impressionante de análogos que têm os seguintes nomes: Ciprolet, Cipraz, Cipralon, Microflocos, Ciproxina, Ciprobay, Ifipro, Ciprofan, Ciproflox ”, etc. Com base na localização da infecção, a gravidade das seguintes formas de medicação pode ser prescrita:
- pomada;
- gota para olhos e ouvidos;
- comprimidos revestidos;
- ampolas de injeções;
- solução para perfusão.
Comprimidos
A forma mais popular de antibiótico ciprofloxacino é os comprimidos. Isto é devido à conveniência de armazenamento, transporte e recebimento de fundos. Ao contrário de injeções intramusculares ou intravenosas da droga, o risco de complicações é significativamente menor. Ao mesmo tempo, os comprimidos não são inferiores em eficácia às ampolas. É preferível usar esta forma de medicação para doenças intestinais, que fornecerá acesso rápido da substância de tratamento ao local da infecção. A casca da droga é projetada para proteger o suco gástrico durante a absorção.
Gotas de olhos e ouvidos
Outra forma popular do antibiótico ciprofloxacina é gotas. É usado se o processo inflamatório ou purulento estiver no olho ou nos ouvidos. As gotas são produzidas sob a forma de uma solução com 0,3% da substância ativa. A ferramenta tem uma cor amarela ou verde-amarela, com a presença de cloridrato de ciprofloxacina em uma quantidade de 3 g.A droga é prescrita para as seguintes doenças:
- blefarite;
- úlcera corneana;
- doenças oculares crônicas;
- conjuntivite bacteriana;
- complicações após cirurgia oftálmica.

Solução de infusão
Para injecção intravenosa do fármaco, é utilizada uma solução para perfusão. Externamente, o produto parece uma suspensão, que é prescrita para crianças para uso oral. A solução tem uma tonalidade clara, ligeiramente verde ou amarela. Um medicamento é administrado ao paciente com um conta-gotas por 30 minutos em uma quantidade de 200 mg e 60 minutos - 400 mg. Este método de administração de drogas é usado para quase qualquer tipo de doença infecciosa.
Pomada
Esta forma de dosagem do antibiótico ciprofloxacina é tipicamente usada no tratamento de doenças oculares. É colocado em pequenas quantidades sob a pálpebra inferior várias vezes ao dia. Com lesões infecciosas na pele, o agente é aplicado 1 vez na área afetada, 1 g cada ou na forma de um curativo compressivo. A duração da medicação é determinada pelo médico assistente, com base na gravidade da condição do paciente, na extensão da lesão e na taxa de regeneração tecidual.

Ampolas de injeções
Para facilitar o armazenamento do medicamento, ele é liberado na forma de ampolas com uma solução que é usada para infusão ou injeções por gotejamento. A norma da medicação depende da doença, por exemplo, 200-400 mg é prescrito para pessoas com danos nos ossos e articulações, infecções urogenitais e danos aos órgãos ENT. Se a região abdominal, trato respiratório, tecidos moles da pele são afetados, uma dose única é de 400 mg.
Instruções de uso
Bactérias infecciosas podem infectar quase qualquer órgão humano. Devido a esta característica, os antibióticos são usados em todas as áreas da medicina por médicos de diferentes especialidades. Dependendo da área afetada e da localização da infecção, apenas a forma de dosagem da droga muda. O moderno antibiótico ciprofloxacino em sua anotação possui um amplo grupo de doenças, para a luta contra a qual deve ser prescrito:
- Doenças infecciosas do aparelho geniturinário: salpingooforite, prostatite, uretrite, cistite, adnexite, pielonefrite.
- Peritonite
- Lesões de ossos e pele: erisipela, furunculose, artrite, úlceras de pressão, osteomielite.
- Diarréia infecciosa.
- Sepse.
- Antraz.
- Órgãos ENT e sistema respiratório: amigdalite, bronquite, otite média, pneumonia, sinusite.
- Doenças infecciosas dos órgãos da visão.

Na odontologia
A necessidade de um antibiótico é determinada pelo médico assistente. Um processo inflamatório e infeccioso pode causar gengivas danificadas após a extração dentária. Para dor de dente normal, o medicamento é prescrito em caso de osteomielite ou periodontite. É altamente recomendável que você tome ciprofloxacina após a ressecção. Muitas vezes, o medicamento é usado com fluxo para tratamento em casa. Um antibiótico é usado para doenças infecciosas e purulentas na forma de comprimidos de 0,25 e 0,5 g.A dose do medicamento deve ser determinada individualmente por um especialista.
Com angina
O antibiótico ciprofloxacina luta ativamente com a maioria das bactérias que podem causar angina: meningococo, pneumococo, bacilo hemofílico. A droga é eficaz mesmo contra cepas resistentes a tetraciclinas, penicilinas, aminoglicosídeos. Com staphylococcus e streptococcus, a droga lida seletivamente, dependendo do tipo de bactéria. Antes de prescrever o medicamento, a inoculação deve ser feita para garantir a eficácia do uso do medicamento.

Para o tratamento da prostatite
A inflamação que ocorre com a prostatite é efetivamente tratada com antibióticos. Muitas vezes, o médico prescreve para tomar ciprofloxacina-promed, que pode ser chamado a principal indicação para se livrar do problema. O medicamento é usado no tratamento da prostatite aguda e crônica em homens em qualquer idade. Recomenda-se tomar a medicação em terapia complexa. A dosagem durante o tratamento é a seguinte:
- Na forma crônica de prostatite, 125 a 750 mg são prescritos duas vezes ao dia por quatro a seis semanas.
- Na forma aguda de prostatite bacteriana, uma dose de 500 mg da droga é prescrita 2 vezes ao dia durante 2 semanas.
Com cistite
As propriedades antibacterianas únicas da ciprofloxacina permitem que a droga seja usada para combater qualquer forma de cistite. Esta ferramenta será a primeira coisa que um médico irá prescrever ao elaborar um curso de terapia. A dosagem e o método de aplicação da droga serão diferentes dependendo da forma da cistite. Sob a forma de comprimidos, de acordo com as regras, a droga é tomada com o estômago vazio, regado com muitos líquidos. A duração do tratamento, a dosagem depende da gravidade da cistite, como regra, é de até 10 dias. O antibiótico é tomado por mais 2 dias após os sintomas desaparecerem.
Doenças otorrinolaringológicas
Órgãos ENT são muito suscetíveis a processos inflamatórios. Por isso, a ciprofloxacina é eficaz no tratamento de tais doenças. O objetivo da droga é permitido somente após os testes apropriados pelo médico. A medicação age na infecção, matando-a. A dosagem de doenças ENT depende da infecção, por via de regra, o doutor prescreve ciprofloxacin na forma de pastilhas de 250 mgs ou 500 mgs.

Contra-indicações e efeitos colaterais
- Você não pode ter uma criança com menos de 18 anos de idade, porque a droga pode afetar o processo de formação do esqueleto.
- Doenças de tendões, ligamentos.
- Durante a gravidez, durante a lactação.
- Não deve ser tomado se ocorrerem ataques de epilepsia.
- Na presença de intolerância pessoal aos componentes do medicamento.
- Não tome ao mesmo tempo que tizandine.
Alguns pacientes estão interessados em saber se é possível beber álcool e tomar o remédio. Deve ser entendido que a ciprofloxacina é um fármaco potente, pelo que a combinação da sua ingestão com álcool é proibida.A interação do medicamento com bebidas fortes pode levar a efeitos colaterais desagradáveis ou uma diminuição na ação dos componentes do medicamento, por exemplo:
- A droga e o álcool têm um duplo efeito tóxico no fígado, destruindo-o.
- A presença de álcool no sangue aumenta o risco de efeitos colaterais.
- A medicação aumenta o efeito do álcool na condição humana, e a eficácia da droga é significativamente reduzida.
Os médicos recomendam fortemente que você desista do álcool não apenas durante o curso da terapia, mas também nos próximos dois dias, para que a medicação seja completamente removida do corpo. A dose diária do medicamento é prescrita pelo médico com base em testes. Existem situações em que ocorrem sintomas de overdose ou ocorrem efeitos colaterais.
Overdose
- dor abdominal
- Tontura
- diarréia
- vômito
- tremor nas mãos;
- dor de cabeça
- alucinações;
- atividade convulsiva;
- sangue na urina;
- insuficiência renal hepática.
Efeitos colaterais
- erupção cutânea, comichão;
- inchaço;
- diarreia, náusea, vômito;
- distúrbio do sono;
- visão dupla;
- disbiose intestinal;
- fraqueza
- hepatite;
- palpitações cardíacas;
- anemia
- tontura.
Vídeo sobre a eficácia da ciprofloxacina
Comentários
Karina, 28 anos O marido tinha uma ferida aberta no rosto, séria. O médico prescreveu ciprofloxacina. O tratamento durou 7 dias, 2 comprimidos por dia. A medicação cumpriu plenamente suas funções - evitou a supuração devido à infecção. Depois de ler os efeitos colaterais, eles ficaram horrorizados, então você deve tomar o medicamento exclusivamente como indicado pelo seu médico. Satisfeito com o baixo preço da droga.
Alena, 32 anos Uma impressão muito dupla da droga. Eles me prescreveram ciprofloxacina para bronquite aguda. A droga me ajudou a curar a doença, mas enquanto tomava o remédio, comecei a ter problemas de pressão e coração. Agora eu gasto dinheiro no tratamento dos efeitos colaterais da medicação. Não tenho certeza de que o baixo custo da ciprofloxacina justifique esse efeito no corpo.
Julia, 25 anos Com a ajuda de ciprofloxacina, ela curou uma amigdalite purulenta crônica, que ela não curou a tempo. O efeito do antibiótico já estava no 2º dia de uso do fármaco, e no 3º da infecção não havia traço. É verdade que me senti constantemente fraco, o tordo apareceu pela primeira vez, o que eu nunca havia sofrido antes. Talvez você deva procurar um remédio com uma lista mais modesta de efeitos colaterais.